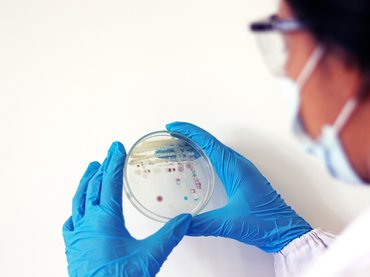
Új halálos fegyverrel támad a klímaváltozás

Lapszemle
Cikkek


Weborvos
A legnehezebb betegem én voltam – kiégés az intenzív osztályon
2025. 08. 07. 04:58

Weborvos
Csak orvosok végezhetik, de autószerelők is megteszik. Mi az?
2025. 08. 06. 05:14

Weborvos
Gyenes Géza: kiemelten fontos visszaállítani a kórházi ellátást
2025. 08. 06. 04:32

